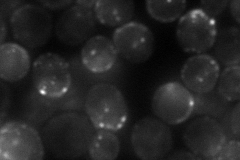
YBR148W
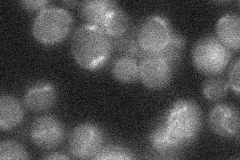
YBR148W
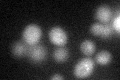
YBR148W

View description
Protein required for normal prospore membrane formation; interacts with Gip1p, which is the meiosis-specific regulatory subunit of the Glc7p protein phosphatase; expressed specifically in spores and localizes to the prospore membrane
Localization:
Intensity:
Fold change:
Significance:
-
C’ GFP library in SD

below threshold16.77 -
N' NOP1pr-GFP in SD
cell periphery,punctate82.5614 -
N' TEF2pr-mCherry in SD

cell periphery,punctate18.1137 -
N' NATIVEpr-GFP in SD
below threshold19.8735 -
N' TEF2pr-VC and Cyto-VN in SD

punctate41.2973 -
C’ GFP library in SD+DTT
cytosol19.111.13No -
C’ GFP library in SD+H2O2

cytosol15.90.94No -
C’ GFP library in Starvation Media

cytosol14.80.88No -
C’ GFP library on the background of Pup2-DaMP

below threshold -
C’ GFP library on the background of CCT mutant

below threshold20.87871.24425No
